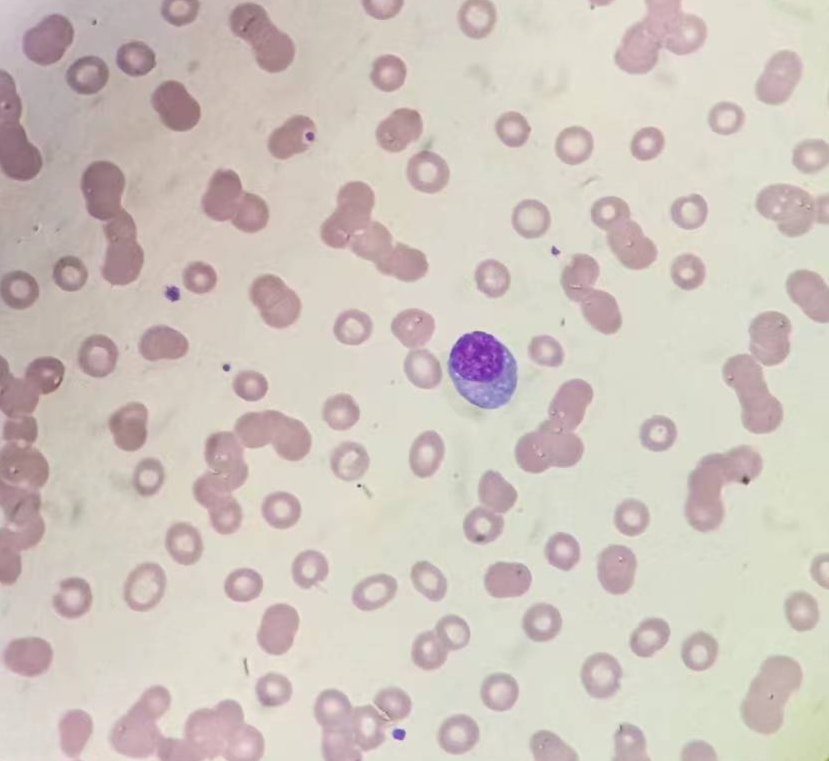

先从一张血常规化验单说起

这是一位70岁的老先生的结果,白细胞及血小板数值都正常,只有血红蛋白值低于正常值,87g/L,说明这位老先生已经属于中度贫血。
那么老年人出现贫血的常见原因有哪些呢?主要可分为以下几点:1造血原料缺乏2炎症性贫血3促红细胞生成素(EPO)不足4恶性肿瘤5药物引起的贫血6难以解释的相关贫血
1.造血原料缺乏 主要包括铁、维生素B12、叶酸等的缺乏。一方面老年人咀嚼能力下降、烹调过度追求“细”、“软”,容易造成营养物质流失;另一方面年人饮食结构不均衡,过分单一,或是胃肠道功能减弱、进食量减少均可导致造血原料缺乏。除饮食因素外,胃肠道病变、胰腺病变、服用某些药物等也常影响营养物质的吸收,导致贫血。 是否有造血原料的缺乏可以到医院进行检查,并且需要找到根本原因,比如有无消化道疾病等,千万不要大意。
2.炎症性贫血 以前叫做慢性病性贫血,常见于慢性感染、风湿性疾病以及其他一些慢性疾病。它们常引起铁的利用障碍而出现贫血。抽血检查中我们可以看到血清铁、总铁结合力减低,血清铁蛋白增高。
3.促红细胞生成素(EPO)不足 EPO是一种刺激因子,主要由肾脏产生,可以刺激骨髓造血。约30%的老年人贫血是由于EPO绝对或相对不足所致,肾脏病变所致EPO产生不足的肾性贫血较多见,贫血是慢性肾功能不全“必有”的症状。全身慢性疾患,如类风湿性关节炎、慢性感染时EPO产生不足或对EPO不敏感导致的老年人贫血也常见。
4.恶性肿瘤 老年人恶性肿瘤所致贫血中,以消化道肿瘤及造血系统肿瘤为多见。 消化道肿瘤可因长期少量慢性失血或急性大出血,导致贫血,特别是检查诊断的缺铁性贫血,进一步检查常发现是由消化道肿瘤所致。因此对于老年男性或绝经后妇女一旦出现缺铁性贫血的表现,一定要追查原因,特别要除外消化道肿瘤。 造血系统肿瘤如白血病、骨髓增生异常综合征、多发性骨髓瘤等在老年人是多见的,特别是多发性骨髓瘤,起病隐匿,有时会以贫血为首发表现,有些患者并不出现明显的溶骨性病灶,免疫球蛋白量的变化亦不明显,常因此而误诊,故对无法解释的贫血患者及时反复行骨髓穿刺和免疫固定电泳检查并跟踪随访是很有必要的。
5.药物引起的贫血 老年人常伴有高血压、冠心病、糖尿病等慢性疾病,需长期用药,最常用的如抗血小板聚集药物阿司匹林,该药长期应用可引起2%左右患者因消化道失血而造成贫血。某些药物如非甾体类抗炎药(如布洛芬、吲哚美辛等止痛药)、β内酰胺类抗生素(如头孢类抗生素)、抗结核药甚至某些静脉用活血化瘀中药等偶尔会通过免疫机制导致溶血性贫血,有时是危及生命的急性血管内溶血,需高度警惕。
6.难以解释的相关贫血 有些老年人贫血的病因并不清楚,或许与肾小球滤过率下降、对EPO的敏感性下降、雄性激素降低(男性和女性)、造血干细胞增殖能力下降等原因相关进而诱发老年人的贫血,一概称为难以解释的老年人贫血(UA)。
那么,就来看看我们这例到底是因为什么贫血的?
首先推片镜检看看
发现红细胞缗钱状排列,一枚标准的浆细胞!

生化结果显示总蛋白与球蛋白偏高!
目前就会考虑浆细胞方面的疾病造成的贫血。
住院进一步检查结果如下
骨髓结果


异常浆细胞占86%。

免疫分型结果显示异常细胞比例83%,主要表达单克隆浆细胞表型。

免疫球蛋白IgG增高。

血清蛋白电泳发现M蛋白条带,占比31.55%。

免疫固定电泳结果显示为IgG lambda型。

最后诊断:多发性骨髓瘤,IgG lambda型。
至此,终于弄明白了这位老先生贫血的真正原因!
由此可见,老年人出现贫血,可以是许多疾病的临床表现之一,甚至是某些疾病的首发表现,应引起我们足够重视,及时就医,积极诊断,尽早治疗。
(作者:孙伟娜)